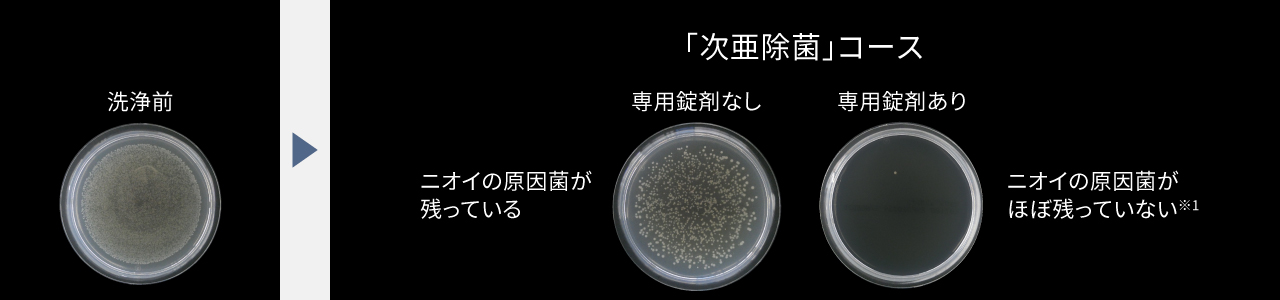
生菌数比較写真：「次亜除菌」コース（専用錠剤なし）だとニオイの原因菌が残っているが、「次亜除菌」コース（専用錠剤あり）だとニオイの原因菌があまり残っていない

縦型洗濯機FAシリーズ特長次亜除菌コース


業界初*専用錠剤**を用いて、衣類と洗濯槽どちらも除菌※1※2
*国内家庭用洗濯機において、専用錠剤を使用しタオルや衣類のニオイの原因菌を除菌。2022年6月25日発売
次亜除菌コースのポイントを動画でご紹介
こんなアイテムにおすすめ
- 汗をかいたスポーツウェア
- ニオイが気になるタオル



ユニフォーム(ポリエステル100%)

ニット(アクリル100%)

肌着(白、綿100%)

室内用スリッパ(白、綿100%)

洗濯槽の除菌※2もできます。
除菌※1※2方法は簡単


洗濯前に、手動洗剤ケースに「次亜除菌コース専用錠剤」**をセット。手軽に除菌※1※2ができます。
次亜除菌コースの使い方
- 次亜除菌コース専用錠剤(別売)**を用意(商品に1錠同梱しています)。
- 手動洗剤ケースの次亜錠剤投入口に1錠入れる。
- 次亜除菌コースで洗濯スタート。
「次亜除菌」コースの行程


*** NA-FA12V6 洗濯容量3.6 kgの場合。NA-FA10K6・FA9K6・FA8K6は約60分、NA-JFA8K6は約61分です。
- 水温によって洗い時間が変化します。
次亜除菌コースで使う専用錠剤について

**
N-Z1
パナソニック タテ型洗濯機 次亜除菌コース専用錠剤(20錠入り)
商品(次亜除菌コース搭載機種のみ)に1錠同梱しているので、すぐに次亜除菌コースを使えます。ぜひ、効果をお試しください。専用錠剤は、量販店やWEBサイトなどで購入できます。

ライオンケミカル(株)製のふろ水清浄剤も使用可能です。
こだわりPOINT
錠剤の主成分はベビー用品の除菌に使われる成分と同じ

【衣類やタオル】
ニオイの原因菌を徹底除菌※1
除菌※1効果

写真はNA-FA12V6 洗濯3 ㎏時、次亜除菌コース(専用錠剤なし)と次亜除菌コース(専用錠剤あり)において、菌液付着試験布の生菌数測定。当社実験による。
洗えるもの

- 綿、麻100%の白物
- ポリエステル、アクリル100%の白物・色柄物
上記の表示があっても、金属類(ファスナーやボタン、フックなど)が付いた衣類は変色のおそれがあるため、洗わないでください。
除菌※1※3ができる2つのコースの使い分け
***NA-FA10K6・FA9K6・FA8K6は約60分、NA-JFA8K6は約61分です。
- 水温によって洗い時間が変化します。
【洗濯槽】
洗濯しながら洗濯槽も除菌※2

洗濯槽の除菌の効果が証明されています。
- 写真はNA-FA12V6です。NA-FA10K6/FA9K6/FA8K6/JFA8K6の洗濯槽内部はマット調仕上げです。
※2 〈次亜除菌コースによる槽除菌〉
[試験機関](一財)日本食品分析センター[試験成績書発行年月日]2022年11月7日・2022年12月15日[試験成績書発行番号]第22053800001-0101号・第22053800002-0101号[試験方法]洗濯・脱水槽および外槽に取り付けた菌液付着試験布の生菌数測定[除菌方法]次亜除菌錠剤を用いた次亜除菌コースによる[対象部分]洗濯・脱水槽および外槽[試験結果]菌の減少率99.9 %以上(自社換算値)。
ここが気になる次亜除菌コースQ&A
Q1. どんな人におすすめのコース?
A1. 衣類の菌やニオイが気になり、気軽に除菌※1※2をしたい人におすすめです。
Q2. 専用錠剤を、洗濯が始まる前に直接洗濯槽内に入れてもいい?
A2. 専用錠剤は、手動洗剤ケースの専用ケース内に入れてください。
専用ケース内に入れずに洗濯槽内に直接入れると、「洗い」行程で錠剤が溶けることとなり、除菌※1※2の性能が保証できません。次亜除菌コースでは、「洗い」「すすぎ」が終了した段階で錠剤を入れることで、しっかり除菌※1※2ができます。また、使用方法を誤ると、衣類が色落ちするおそれがあります。
Q3. 除菌ができる他のコースとの違いは?
A3. 「次亜除菌」コースは、約66分***で洗濯も除菌※1※2もできるので、日常使いにおすすめです。
*** NA-FA12V6の場合。 NA-FA10K6・FA9K6・FA8K6は約60分、NA-JFA8K6は約61分です。
- 水温によって洗い時間が変化します。
縦型洗濯機 その他の特長
★1〈 約40 ℃においスッキリコースによる消臭〉[試験機関]近江オドエアーサービス(株)[試験方法]部屋干し臭が付着したタオルハンカチを6段階臭気強度表示法にて評価 [消臭方法]高濃度洗剤液と加熱温水洗浄による [対象部分]洗濯・脱水槽内の衣類 [試験結果]「おまかせ」:3.3、「においスッキリ(約40 ℃)」:1.3。
★2 すべての汚れに効果があるわけではありません。衣類や汚れの種類・水温によって効果が異なります。
※1 〈次亜除菌コースによる衣類除菌〉[試験機関](一財)日本食品分析センター[試験成績書発行年月日]2022年2月15日[試験成績書発行番号]第21020925001-0101号[試験方法]菌液付着試験布の生菌数測定[除菌方法]次亜除菌錠剤を用いた次亜除菌コースによる[対象部分]洗濯・脱水槽内の衣類[試験結果]菌の減少率99.9 %以上(自社換算値)。衣類上のにおいの原因菌において。全ての菌に効果があるわけではありません。
※3 〈約40 ℃においスッキリコースによる除菌〉 [試験機関](一財)日本食品分析センター [試験成績書発行年月日]2017年12月7日[試験成績書発行番号]第17117220001-0101号 [試験方法]菌液付着試験布の生菌数測定[試験結果]菌の減少率99 %以上(自社換算値)。









